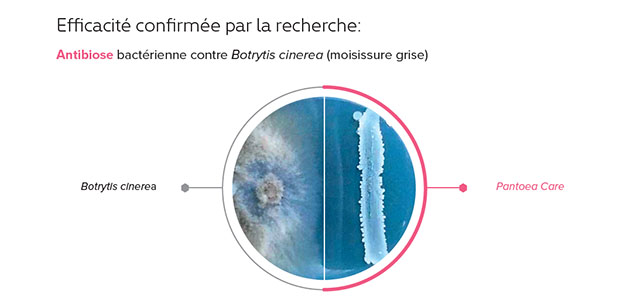
Bactim pantoea care label 4

Engrais Microbiologique - Bactim Pantoea Care
Est un produit microbiologique contenant des souches uniques de bactéries Pantoea spp., caractérisées par leur capacité à coloniser rapidement les parties aériennes des plantes, formant ainsi une barrière naturelle limitant la nocivité des agents pathogènes. Ces bactéries produisent des métabolites actifs qui renforcent l’immunité naturelle des plantes, améliorant ainsi leur santé, leur développement, leur rendement et leur durée de conservation après récolte.

Les principaux effets bénéfiques de BACTIM® PANTOEA CARE sont :
- une nocivité limitée des agents pathogènes
- une meilleure résistance des plantes aux conditions de stress
- une amélioration de la santé et du développement des plantes
- une augmentation du rendement et de la durée de conservation après récolte

Bactim Pantoea Care
Est un produit microbiologique contenant des souches uniques de bactéries Pantoea spp., caractérisées par leur capacité à coloniser rapidement les parties aériennes des plantes, formant ainsi une barrière naturelle limitant la nocivité des agents pathogènes.
Bactim Endofix
Est un produit unique a base de bactéries endophytes Paenibacillus polymyxa, qui pénètrent dans les tissus internes des plantes, en leur fournissant de l’azote supplémentaire et des substances bio stimulantes telles que: phytohormones, acides aminés, enzymes et protéines.
Mycotim Nemablock
Est un bioproduit contenant des consortiums uniques de champignons mycorhiziens et de bactéries de la rhizosphère.